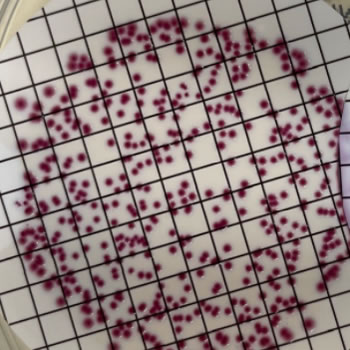

About us
WATERNOW - italian water solutions
I sistemi di depurazione dell’acqua AQA+ rendono l’acqua microbiologicamente sicura senza utilizzo di disinfettanti.
Il rischio di proliferazione di legionella e microrganismi patogeni aumenta con l’utilizzo di un serbatoio, ed in particolare quando vi è un impiego non continuativo di tutti i punti acqua.
AQA+ utilizza tecnologie GREEN a basso impatto ambientale.
- Il sistema è pensato per adeguarsi a spazi ridotti
- Facile da installare, anche da parte dell’utente finale in autonomia

Pre trattamento
Post trattamento

Semplice
Installazione e facilità d'uso
Alimentazione
Alimentazione 12/24/220 V batteria adatta a spazi ristretti e privi di cablaggi elettrici.
Qualità
Materiali di alta qualità, piedi antivibranti, sistema di monitoraggio da remoto con app dedicata.
Applicazioni
Scopri le molteplici applicazioni


-
Condomini
-
Case Vacanza
-
Campeggi
-
Nautica
-
Camper e caravan
Scopri di più
Contattaci per maggiori informazioni
Legionella
PROTEGGITI DAL RISCHIO LEGIONELLOSI
NON SOTTOVALUTARE IL RISCHIO LEGIONELLOSI, RICHIEDI ORA LA NOSTRA VALUTAZIONE GRATUITA PER LA TUA ABITAZIONE, CONDOMINIO O AZIENDA
L'acqua è un bene indispensabile, ma sfortunatamente non è sempre sicura. Con il Decreto Legislativo 23 febbraio2023, n. 18, si introduce l’obbligo di un piano di sicurezza dell’acqua e il monitoraggio di legionella in numerose strutture industriali e abitative.
- La Legionella è un genere di batteri che vive negli impianti idrici sanitari e prolifera rapidamente in presenza di acqua stagnante e calcare.
- Le fonti principali di rischio per l’uomo, infatti, sono le docce, le piscine, le vasche idromassaggio e gli impianti di condizionamento.
- La legionellosi è un’infezione in costante aumento che può comportare un rischio grave per la salute umana.
COMPILA IL QUESTIONARIO GRATUITO
Ricevi il nostro modulo GRATUITO per la valutazione del Rischio Legionellosi
Contatti
Contattaci
Indirizzo
Via Guido Reni, 4
20038 - Busto Garolfo (MI)
Inserisci i tuoi dati per essere ricontattato

